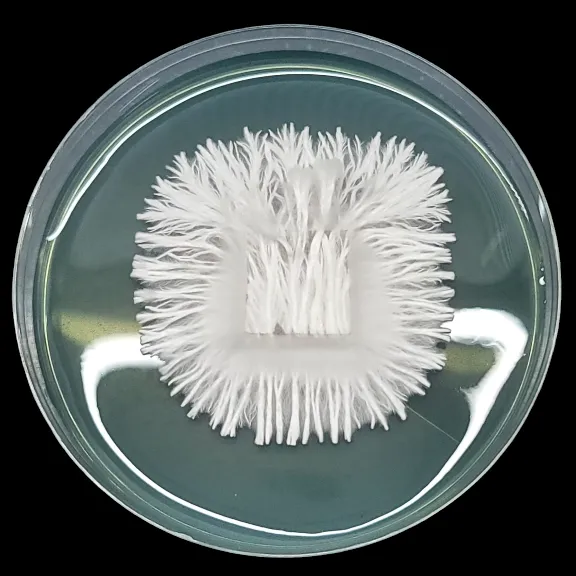

Enigma – Strain Profile & History
Enigma is one of the most unusual and recognizable mutations in the Psilocybe cubensis world. Unlike typical cubensis, it doesn’t produce mushrooms in the traditional sense
The Story of Enigma
In 2018, a mycologist named Boomer Smith received a spore syringe from Magic Myco, a vendor and researcher experimenting with blends of different Cubensis lineages. That syringe reportedly contained spores of Tidal Wave and Penis Envy, and from it came something truly unusual: a coral-like mutation that didn’t look like any cubensis before it.
From this experiment came something no one expected: a fin-like, coral-like mutation that looked nothing like the cubensis forms we know. Boomer immediately recognized it as something extraordinary. He began sharing photos on Facebook, Shroomery, and Instagram, sparking fascination across the community.
But the discovery soon sparked debate. Some wanted to protect and covet the culture, fearing its potential for profit. Others felt it should be shared freely, as a gift to the community. At the same time, questions of ownership began to surface, Boomer had discovered it, but Magic Myco was the source and soon began promoting the same culture under a different name: Tidal Wave 2. We see both sides, the genetic source and the first to grow/ clone this. This kind of situation with mushroom genetics can happen. Two perspectives and approaches to a strains future.
In the middle of this, one of Boomer’s friends passed along a plate of Enigma mycelium, an act some might call reckless, but one that ensured the mutation wouldn’t vanish into obscurity. That plate found its way to Basidium Equilibrium.


The Story of Enigma
Our Position on enigma: At Basidium Equilibrium, we make no claims of ownership over Enigma. We were simply there to witness its emergence and to help preserve it when the future of the strain was uncertain.
In early 2019, small groups of mycologists, ourselves included, began to distribute Enigma cultures in bulk. At Basidium Equilibrium, we released over 400 isolated plates at cost, shipping them out for only a few dollars to cover materials. The goal was simple: make sure this extraordinary mutation didn’t vanish into obscurity.
Since then, Enigma has cemented its place in mycology. It does not produce spores, remaining a stable but sterile mutation.
Magic Myco named his version of the mutation as “Tidal Wave 2.” Under this name, it went on to win the Psilocybin Cup, outperforming other entries and cementing its reputation. For us, Enigma remains both a scientific curiosity and a living reminder of how diverse fungal expression can be.
Our View: Whether called Enigma or Tidal Wave 2, this strain carries both stories. We see value in recording them both and leaving the legacy of Enigma where it belongs, with the community.
Morphology & Traits
1. Growth Form: Forms dense, coral-like or brain-like tissue masses.
2. Spore Production: None. Enigma is completely sterile and can only be propagated via tissue culture.
3. Bruising: Strong blue bruising when handled or damaged.
4. Flush Performance: Stable but unconventional; produces undifferentiated tissue instead of mushrooms.
5. Phenotype Notes: Often compared to a “fungal cancer” not harmful to humans, but a mutation that reflects a break from the normal cubensis connection to sun, spores, and natural reproduction.
Observational Notes
- Enigma remains stable across transfers and plates, a rare feature for a mutation.
- Its inability to reproduce independently makes it an outlier in the fungal kingdom—living on only because humans continue to clone and share it.
- For researchers, it offers a living case study in mutational biology and sterility in fungi.

Cultural Significance
Enigma is more than a mutation; it’s a symbol of the modern myco community. Its story is tied to friendship, conflict, generosity, and the tension between commerce and open-source sharing. From its chaotic debut in 2018, through the plate drops of 2019, to its victory at the Psilocybin Cup, Enigma has carved out its place as one of the most memorable discoveries in cubensis history.
Enigma stands apart as a genetic mystery. Born from a hybrid syringe, stabilized in strange coral-like tissue, and kept alive only through cloning, it embodies both the fragility and resilience of fungal genetics. Whether you see it as a mutation, a miracle, or a kind of fungal cancer, Enigma is a reminder that fungi are full of surprises and that the stories behind these genetics are just as fascinating as the organisms themselves.

🔍 Enigma: Myth vs. Fact
Myth: Enigma is just another Tidal Wave variant.
Fact: While its syringe of origin may have contained both Tidal Wave and Penis Envy spores, Enigma is a unique mutation that produces coral-like tissue, not traditional mushrooms.
Myth: Enigma can be grown from spores.
Fact: Enigma is completely sterile. It has never produced spores and can only be propagated by tissue cloning.
Myth: Enigma’s origins are clear and undisputed.
Fact: The strain sparked controversy between Boomer Smith and Magic Myco, with debates about ownership, naming, and whether it should be freely shared or monetized. But all philanthropy has its limits.
Myth: Enigma is a “new strain.”
Fact: It’s not a strain in the classic sense but a stable mutation of cubensis, a genetic anomaly preserved by the community.









